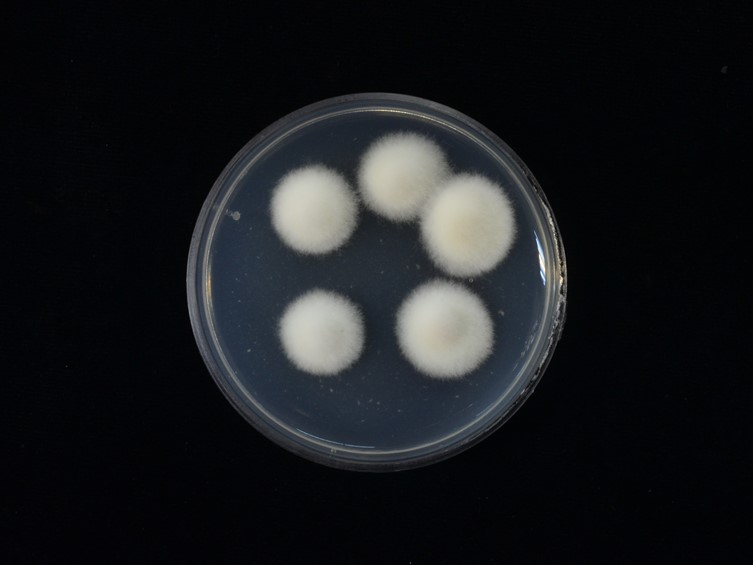

Holotype:
THAILAND, Tak Province, Mae Sot District, 6 Sep. 2018, K. Tasanathai, S. Mongkolsamrit, W. Noisripoom, D. Thanakitpipattana, holotype BBH 44500, ex-type living culture BCC 89300.
Habitat:
In leaf litter.
Host:
Larva (Lepidoptera).
Description:
 Stroma arising from the middle joints of the Lepidoptera larvae, solitary, cylindrical, 26 mm long, 1-1.5 mm wide. Stipe cylindrical, club-shaped, purple base to whitish-purple, fertile part deep vinaceous.
Stroma arising from the middle joints of the Lepidoptera larvae, solitary, cylindrical, 26 mm long, 1-1.5 mm wide. Stipe cylindrical, club-shaped, purple base to whitish-purple, fertile part deep vinaceous.  Perithecia semi-immersed, oblique in arrangement, ovoid, hyaline wall, 360-470 × 260-320 μm.
Perithecia semi-immersed, oblique in arrangement, ovoid, hyaline wall, 360-470 × 260-320 μm.  Asci hyaline, cylindrical, 100-192.5 × 3-6 μm.
Asci hyaline, cylindrical, 100-192.5 × 3-6 μm.  Ascospores smooth, filiform, hyaline, whole, multi-septate, 107-177.5 × 1 μm. Asexual morph not seen in nature.
Ascospores smooth, filiform, hyaline, whole, multi-septate, 107-177.5 × 1 μm. Asexual morph not seen in nature.
Culture characteristics:
Colonies on PDA attaining a diam of 15 mm in 7 d, white to creamy, cottony. Hyphae septate, rough-walled, hyaline, 1–2 μm wide. Phialides arising from aerial hyphae, lecanicillium-like, hyaline, solitary or up to 2 per branch, narrow, cylindrical, tapering gradually towards the apex, 7–22 × 1–2 μm. Conidia in long chains, hyaline, ovoid to globose, 2–4 × 1.5–2 μm.
Colonies on PDA attaining a diam of 15 mm in 7 d, white to creamy, cottony. Hyphae septate, rough-walled, hyaline, 1–2 μm wide. Phialides arising from aerial hyphae, lecanicillium-like, hyaline, solitary or up to 2 per branch, narrow, cylindrical, tapering gradually towards the apex, 7–22 × 1–2 μm. Conidia in long chains, hyaline, ovoid to globose, 2–4 × 1.5–2 μm.
Reference:
Mongkolsamrit S, Khonsanit A, Thanakitpipattana D, et al. (2020). Revisiting Metarhizium and the description of new species from Thailand. Studies in Mycology 95: 171–251.
DOI: https://doi.org/10.1016/j.simyco.2020.04.001Species |
Strain |
Compound |
Pubchem CID |
Biological activity |
Reference |
|---|
|
Strain |
ITS | LSU | RPB1 | RPB2 | TEF1 |
|---|---|---|---|---|---|
| BCC 88441 | MN781916 | MN781877 | MN781779 | MN781824 | MN781734 |
| BCC 89300 | MN781917 | MN781876 | MN781778 | - | MN781733 |